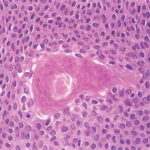

Eccrine poroma = ورم مسامي ناتح
POROMA
The term poroma refers to a group of rare cutaneous appendage tumors composed of cells (cuticular and poroid cells) similar to those of the acrosyringium. Poromas are traditionally subcategorized histopathologically based on their location in relation to the epidermis into three main variants; namely, hidroacanthoma simplex, eccrine poroma, and dermal duct tumor. Some authors add poroid hidradenoma to this group. There are also reports of “poromas” with differentiation toward the folliculosebaceous-apocrine unit.
Clinically, hidroacanthoma simplex presents mostly in middle-aged and elderly individuals, preferentially in women as a solitary, hyperkeratotic plaque, with predilection for the extremities. Eccrine poroma occurs commonly as a solitary, slowly growing, skin-colored, or pigmented sometimes bright red, itchy, or painful pedunculated, sessile papule or nodule, situated mostly on the soles and palms of adults
Histopathology.
Hidroacanthoma simplex shows sharply demarcated aggregations of cuboid to ovoid cells confined to the epidermis. Eccrine poroma reveals aggregations of uniform basaloid cells that radiate from the basal layer of the epidermis into the dermis . Dermal duct tumor consists of several sharply circumscribed, mainly dermal nodules composed of poroid and cuticular cells. Ductal structures are frequently observed. Poroid hidradenoma is characterized by intradermal, solid, and cystic aggregations of poroid cells.
Prognosis and Clinical Course.
Eccrine poroma is rarely observed to precede the development of porocarcinoma.
Treatment.
Treatment of choice is total surgical excision.